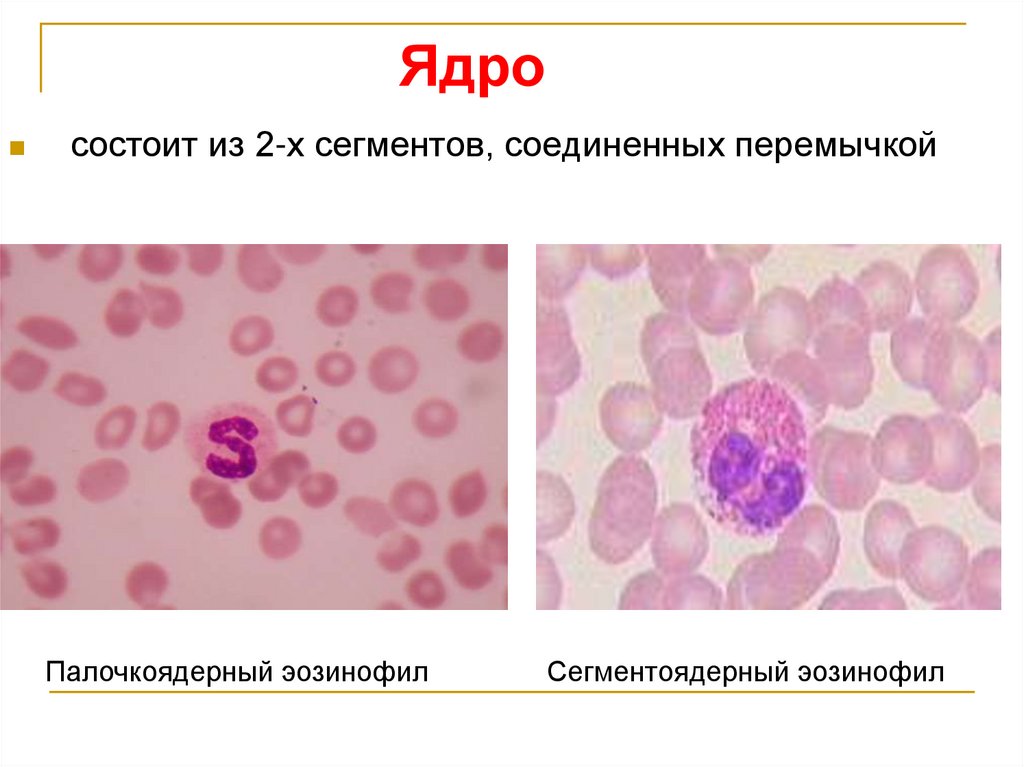
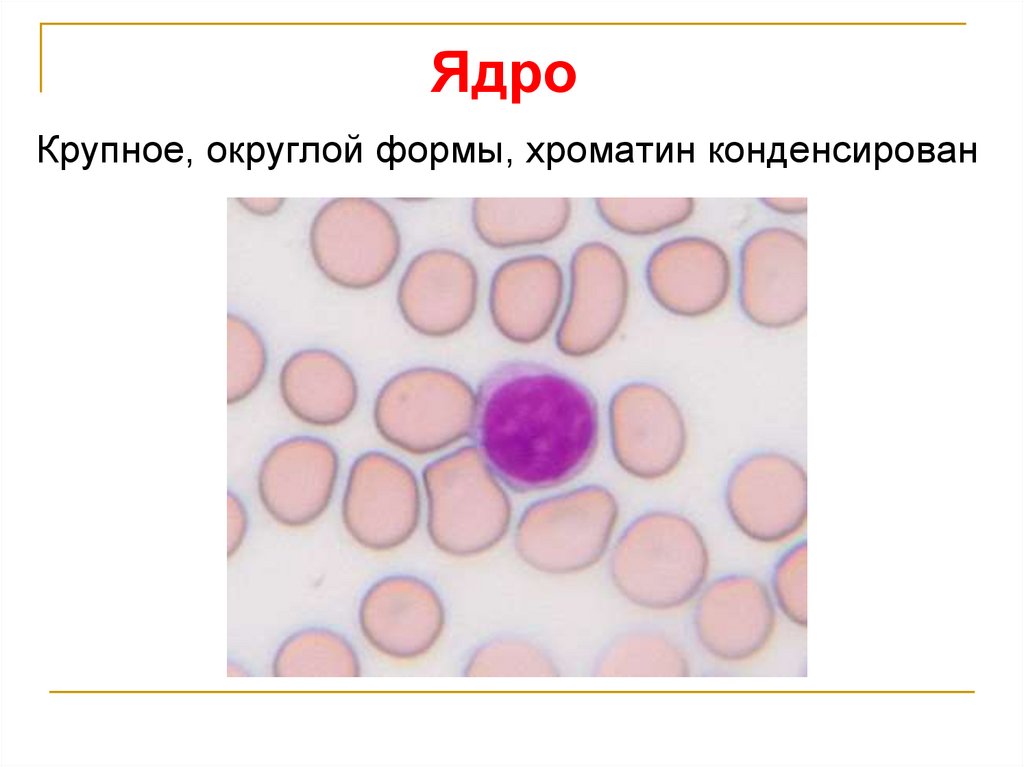
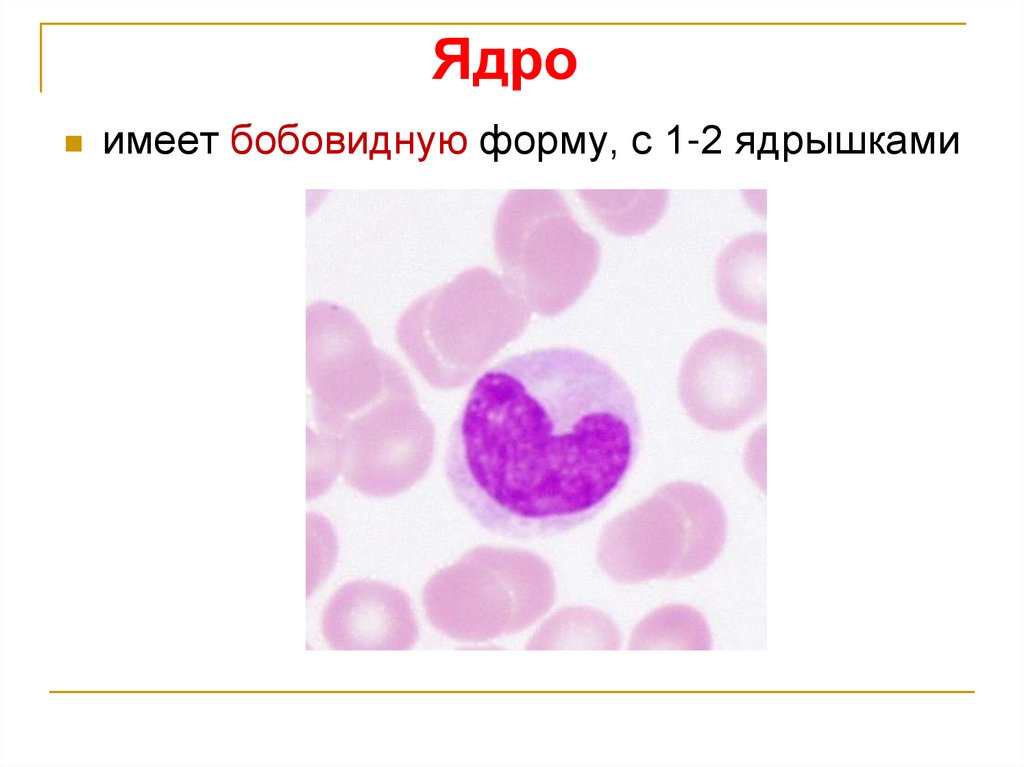

Похожие презентации:
Кровь и лимфа. Общая характеристика крови
1. КРОВЬ И ЛИМФА
2. Общая характеристика крови
Кровьи лимфа
относятся
внутренней среды организма.
к
тканям
Кровь составляет 6-8% массы тела (около 5-
5,5 л у взрослого человека).
Источник развития – мезенхима.
3.
Функции крови1) Транспортная
Дыхательная – перенос кислорода от легких к тканям и
углекислоты от тканей к легким.
Трофическая – питательные вещества поступают в организм с
пищей, затем расщепляются в желудочно-кишечном тракте до
белков, жиров и углеводов, всасываются и переносятся
кровью к различным органам и тканям.
Экскреторная – удаление продуктов метаболизма.
Регуляторная – перенос гормонов, факторов роста и др.
Терморегуляторная – распределение тепла между органами
и его выделение во внешнюю среду.
4.
Функции крови2) Защитная
Кровь обеспечивает гуморальный и клеточный иммунитет,
фагоцитоз.
3) В совокупности эти функции обеспечивают гомеостаз
(постоянство внутренней среды организма).
5.
Компоненты крови:1) Плазма – жидкое межклеточное вещество 55-60 % объёма крови
2) Форменные элементы – 40-45% :
эритроциты
тромбоциты
лейкоциты
постклеточные структуры
6.
Гемограмма – это абсолютное содержаниеформенных элементов в расчете на 1л крови
Показатели
гемограммы
Взрослого
Новорожденного
Эритроциты
Муж. 3,9-5,5x1012/л
Жен. 3,7-4,9x1012/л
6-7x1012/л
Лейкоциты
4-9x109/л
10-30x109/л
Тромбоциты
180-320x109/л
180-32x*109/л
7. ПЛАЗМА КРОВИ
–межклеточное
вещество
жидкой
консистенции:
1) 90-93% воды
2) 7-10% сухого вещества:
белки – 6,6 – 8,5%,
органические и минеральные вещества – 1,5-
3,5% (углеводы, липиды электролиты).
8. Основные белки плазмы
Альбумины – количественно преобладающие,переносят метаболиты, гормоны, ионы.
Глобулины (ά- и β-) – переносят ионы металлов и
липиды;
γ-глобулины
–
представляют
собой
фракцию
антител (иммуноглобулинов).
Фибриноген – обеспечивает свертывание крови.
9. Эритроциты
10.
Количество эритроцитов в 1 л крови:у мужчин – 3,9-5,5х 10 12/л,
у женщин – 3,7-4,9 х 1012/л.
Продолжительность жизни – до 120
суток, на Севере - 70-90 суток.
11. Эритроциты (красные кровяные тельца)
двояковогнутойформы (необходима для
увеличения
поверхности
и
создания
оптимальных условий для газообмена).
Не содержит ядра и органелл.
Содержит гемоглобин.
Функции: перенос кислорода из легких в
ткани и углекислого газа – из тканей в
легкие
12. Гемоглобин
Гемоглобин–
дыхательный
пигмент.
Состоит
из
белка
глобина
и
железосодержащей
части
гема,
связывающего кислород.
Фетальный HbF – преобладает у плодов, у
взрослых около 2%.
Дефинитивный HbA – у взрослого человека
составляет 98%.
13. Размеры эритроцитов
Нормоциты (75%) – 7,1-7,9 мкм (7,5 мкм)Макроциты (12,5%) – > 8 мкм
Микроциты (12,5%) – < 6 мкм
Появление в крови эритроцитов различной
величины называется анизоцитозом.
14. Ретикулоциты
При специальномсуправитальном
окрашивании в
цитоплазме молодых
эритроцитов выявляются
зернисто-клеточные
структуры (Substantia
reticularis), отсюда
название их –
ретикулоциты.
15.
Ретикулоцитымолодые формы эритроцитов.
Созревание ретикулоцитов происходит в
течение 2-х суток после выхода из ККМ и
заключается в завершении синтеза
гемоглобина и разрушении остатков
органелл.
В норме ретикулоциты составляют до
1% всех эритроцитов.
16. Лейкоциты (белые кровяные клетки)
17. Общая характеристика лейкоцитов
Количество лейкоцитов в 1 л крови –4-9х109
Все
лейкоциты имеют сферическую или
шаровидную форму.
Все
лейкоциты функционируют в тканях и
выполняют защитную функцию.
18. Классификация лейкоцитов
1)Зернистые
имеют
лейкоциты
сегментированное
(гранулоциты)
ядро
и
специфические гранулы в цитоплазме.
2) Незернистые лейкоциты (агранулоциты)
содержат лишь неспецифические гранулы;
специфические гранулы отсутствуют. Ядро
несегментировано.
19. Классификация лейкоцитов
1. Зернистые (гранулоциты):Нейтрофилы
Эозинофилы
Базофилы
2. Незернистые (агранулоциты):
Лимфоциты
Моноциты
20.
Лейкоцитарная формула- это процентное содержание различных форм
лейкоцитов (к общему числу лейкоцитов, равному
100%)
Гранулоциты
Нейтрофилы
Юные Палочко- Сегментоядерные ядерные
0-0,5%
1-6%
48-78%
Агранулоциты
Эозинофилы
Базо- Лимфо- Монофилы циты
циты
0,5-5%
0-1%
20-35%
6-8%
Сдвиг лейкоцитарной формулы влево – это увеличение
процента юных и палочкоядерных нейтрофилов
21. Нейтрофильные гранулоциты (нейтрофилы)
самые многочисленные, составляют у взрослых- 48-78% (2-5,5x109/л).
Продолжительность
жизни– циркулируют в
кровотоке – 8-12 ч, в тканях – 5-7 сут.
Размеры - в мазке крови 10-12 мкм, в свежей
капле крови – 7-9 мкм.
22. Нейтрофильные гранулоциты
По степени зрелости:(показателем зрелости служит степень сегментации ядра)
сегментоядерные
палочкоядерные
юные
23. Цитоплазма
2 типа гранул:1) азурофильные (первичные, неспецифические)
(0,4 мкм) – содержат кислую фосфатазу.
2)
специфические
(вторичные)
(0,2
мкм)
–
содержат лизоцим, щелочную фосфатазу, белок
лактоферрин.
24. Функция нейтрофилов
Главная функция нейтрофилов- фагоцитоз
бактерий и мелких частиц – «тканевых обломков».
Поэтому нейтрофилы называют микрофагами.
25. Нейтрофил
26. Эозинофильные гранулоциты (эозинофилы)
составляют 0,5-5% (0,02-0,3x 109/л)Продолжительность
жизни
-
в
крови
находятся 7-12 ч, в тканях 8-12 суток.
Размеры: в мазке крови - 12-14 мкм,
в свежей
капле крови – 9-10 мкм.
По степени зрелости: юные, палочкоядерные и
сегментоядерные.
27. Ядро
состоит из 2-х сегментов, соединенных перемычкойПалочкоядерный эозинофил
Сегментоядерный эозинофил
28. Цитоплазма
2 типа гранул:1)азурофильные (первичные, неспецифические)
2) специфические эозинофильные гранулы,
которые окрашиваются кислыми красителями.
29. Гранулы эозинофилов
Специфическиегранулы (0,6-1 мкм), имеют
кристаллоид,
главный
основной
(азурофильные)
гранулы
содержащий
белок, богатый аргинином.
Неспецифические
мелкие,
гомогенные,
кислую фосфатазу.
содержат
гистаминазу,
30. Функции эозинофилов
Специфическая функция – антипаразитарная.При
контакте с паразитами выделяют на их
поверхности ферменты, способные разрушать
кутикулу
паразитов,
нейтрализовать гистамин.
убивать
бактерии,
31. Эозинофил
32. Базофильные гранулоциты (базофилы)
Составляют 0-1% (0-0,06x 109/л)Продолжительность
жизни
-
в
кровотоке - до 1 сут, в тканях - до 1-2 сут.
Размеры:
в мазке 11-12 мкм, в капле
свежей крови около 9 мкм.
33. Ядро
сегментировано, имеет 2-3 дольки.34. Цитоплазма
гранулы:1) азурофильные
2) специфические
метахромазией.
Метахромазия
гранулы,
обладающие
– это свойство структур
окрашиваться в цвет, не характерный для
красителя.
35. Гранулы базофилов
1) специфические гранулы (0,5-1,2 мкм) –крупные, метахроматические, содержат гепарин,
гистамин, пероксидазу, факторы хемотаксиса
эозинофилов и нейтрофилов.
2)
неспецифические
гранулы
протеолитические ферменты.
-
содержат
36. Специфические гранулы
37. Функции базофилов
Регуляторная и гомеостатическая выделяют биологически активные вещества:гепарин
препятствует свертыванию крови,
предотвращает образование сгустков и
фибрина.
гистамин
повышает
проницаемость
основного вещества соединительной ткани,
способствует развитию отеков, воспаления,
расширяет стенки кровеносных сосудов.
38. Агранулоциты: Лимфоциты
Составляют 20-35% (1,0-4,0x109/л)Продолжительность
жизни
нескольких дней до десятков лет.
-
от
Размеры:
малые лимфоциты (4,5-6 мкм),
средние лимфоциты (7-10 мкм) и большие
лимфоциты (свыше 10 мкм).
Большие
лимфоциты
–
в
крови
новорожденных и детей, у взрослых
отсутствуют.
39. Ядро
Крупное, округлой формы, хроматин конденсирован40. Лимфоцит
41. Лимфоциты
Классификация по функциональному признаку:Т-лимфоциты
иммунитет,
– обеспечивают клеточный
регулируют
гуморальный
иммунитет.
В-лимфоциты
– выработка антител, т.е.
иммуноглобулинов (гуморальный иммунитет).
42. Т - лимфоциты
Т-киллерыосуществляют
клеточный
иммунитет (уничтожение клеток-мишеней
при непосредственном контакте).
Т-хелперы – способствуют пролиферации и
дифференцировке других лимфоцитов.
Т-супрессоры
лимфоцитов
(лимфокинов).
– угнетают функции разных
посредством
медиаторов
43. Моноциты
Составляют – 6-8%Продолжительность жизни:
в кровотоке - 12-32 ч, в тканях - до 1 месяца.
Размеры:
в мазке - 18-20 мкм, в свежей
капле – 9-12 мкм.
44. Ядро
имеет бобовидную форму, с 1-2 ядрышками45.
Моноцит46. Функции моноцитов
Обладают высокой фагоцитарной активностью.Являются источниками макрофагов различных
органов.
Разрушают
собственные ткани, отмершие
после
болезни,
очищают
организм
от
продуктов распада.
47.
Кровь человека (мазок)48.
Лейкоциты49.
50. Показатели лейкоцитарной формулы в %
Показателивзрослого
ребенка
4-5 дней
1-2 года
4-5 лет
12-14 лет
Нейтрофилы
Всего
Из них:
П/я
С/я
48
≈45
≈25
≈45
48-78
1-6
47-72
≈1-6
≈39-44
≈1-6
≈19-24
≈1-6
≈39-44
1-6
47-42
Эозинофилы
0,5-5
0,5-5
0,5-5
0,5-5
0,5-5
Базофилы
0-1
0-1
0-1
0-1
0-1
Лимфоциты
19-37
45
65
45
19-37
Моноциты
3-11
3-11
3-11
3-11
3-11
51. Тромбоциты
Тромбоциты, или кровяные пластинки –мелкиедвояковыпуклые безъядерные постклеточные
структуры (2-4 мкм).
Тромбоциты - это
фрагменты цитоплазмы
мегакариоцитов - гигантских клеток красного
костного мозга.
Количество 180-320х109/л
Продолжительность жизни – 5-8 дней.
52. Строение тромбоцитов
В окрашенном мазке имеют бледно-голубойцвет.
Состоит из 2 частей:
1) гиаломер (светлая периферическая часть),
2) грануломер (зернистая часть).
53. Специфические гранулы
Представлены следующими 3 типами:1) α-гранулы (альфа-гранулы) – диаметр 300-500 нм.
2) δ-гранулы (дельта-гранулы) – диаметр 250-300 нм.
3) λ-гранулы – типичные лизосомы - диаметр 200-250
нм.
54. Строение тромбоцитов
5 видов тромбоцитов:юные (1-5%),
зрелые (88%),
старые (4%),
дегенеративные (до 2%),
гигантские (2%).
55. Функции тромбоцитов
1) Остановка кровотечениястенки сосудов.
2)
Обеспечение
(гемокоагуляции).
3) Участие
воспаления.
в
при
повреждении
свертывания
реакциях
заживления
крови
ран
и
4) Обеспечение нормальной функции сосудов
(ангиотрофическая функция).
56. Лимфа
Состав:Лимфоплазма
содержит воду, органические
вещества и минеральные соли.
Форменные элементы:
90% лимфоциты,
5% - моноцитов,
2% - эозинофилов,
1% - сегментоядерных нейтрофилов,
2% - др.клеток
57. Лимфа: функции
1) Гомеостатическая – постоянство микроокружения2) Метаболическая – регуляция обмена веществ,
транспорт метаболитов, белков, ферментов, воды,
минеральных
веществ,
биологически
активных
веществ
3) Трофическая – транспорт питательных веществ
4)
Защитная
–
участие
в
иммунных
транспорт антител, лимфоцитов, макрофагов
реакциях,

Медицина
Медицина








